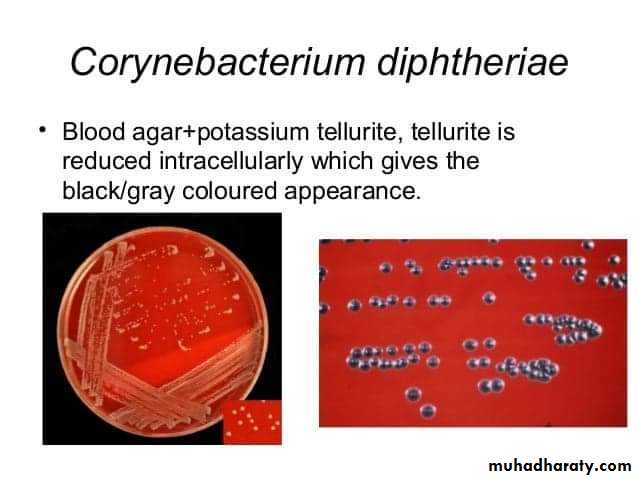
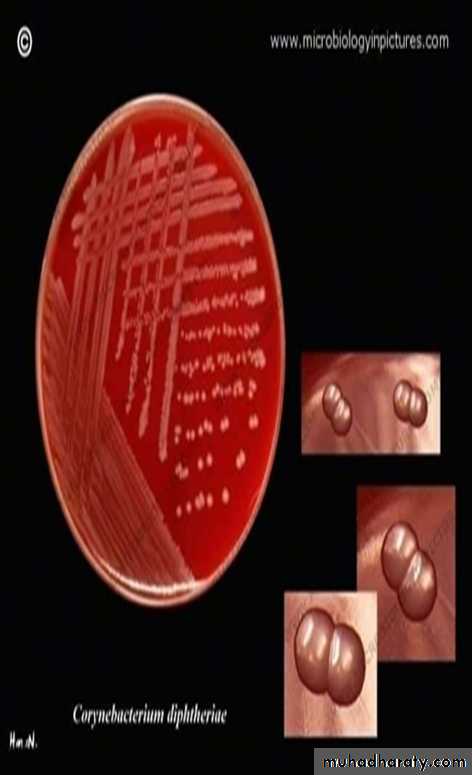
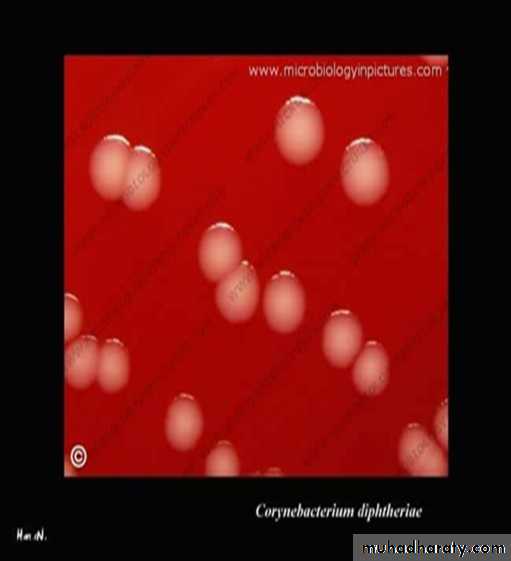

Genus : Corynebacterium
Only one member of this genus, Corynebacterium diphtheriae is pathogenic to man ( caused diphtheria : pharyngitis and bilaterally enlarged cervical lymph nodes ), { polypeptide exotoxin causes diphtheria not the organism }.
Non – pathogenic Corynebacterium species are part of the normal flora in the respiratory tract, skin and other mucous membrane.
Corynebacterium diphtheriaeMICROSCOPICAL APPEARANCE :
Gram – positive, rod shaped of variable size often showing irregular expansion at one or both ends “ club – shaped “.0.6 – 0.8 µ diameter and 3 – 6 µ length.
Pleomorphic rods tend to join together at angles or parallel to each other giving the appearance of Chinese – letters : L or V or Y shape, or arrangement in palisades .
Non motile, non capsulate and non spore forming.
Contain bluish – black metachromatic called ( Volutin ) granules, which can be demonstrated by specific staining technique ( e.g., Albert´s method ).
Albert´s staining method :
• Apply Albert´s stain to a fixed smear, allow to act for 3 – 5 min.• Wash with water blot dry.
• Apply Albert´s iodine, allow ta act for 1 min.
• Wash with water blot dry and examine under oil – immersion lens.
Result :
The bacilli appear light green in color, while the metachromatic granules appear bluish – black.
CULTURAL CHARACTERISTICS :
Aerobic, optimum temperature is 37 °C.The microorganism grows on :
1. Selective media ( Tellurite – Blood Agar) :
Such as potassium tellurite ( with added blood or serum ), the colonies are gray / black colored appearance since they reduce the tellurite within the bacterial cells to telluride.
** Differential for tellurite reduction, so there are three morphological biotypes of C. diphtheriae depending on colony morphology : gravis, intermedius and mitis.
** Colonies appears after 48 hours.
2. Enriched media :
A. Loeffler´s medium :** Developed by Friedrich Loeffler in 1887 and modification by Buck in 1940 to enhance the growth of C. diphtheria.
** Consist of beef serum, heart muscle, peptone, sodium chloride, dextrose and egg.
** Enhances the formation of metachromatic granules within the cell of these microorganisms.
** C. diphtheriae grows rapidly in 6 – 8 hours, colonies are small circular, white or creamy and glistening.
2. Blood agar :
** The colonies are small, gray or gray white, convex, raised translucent and have a very small zone of beta hemolysis.TOXIGENICITY TEST :
Can be determined either by :1. In Vivo Test :
Intradermal inoculation of an animal ( e.g. rabbit or guinea pig ), with the isolated or to demonstrate the effect of its exotoxin ( e.g. local erythema and necrosis ).